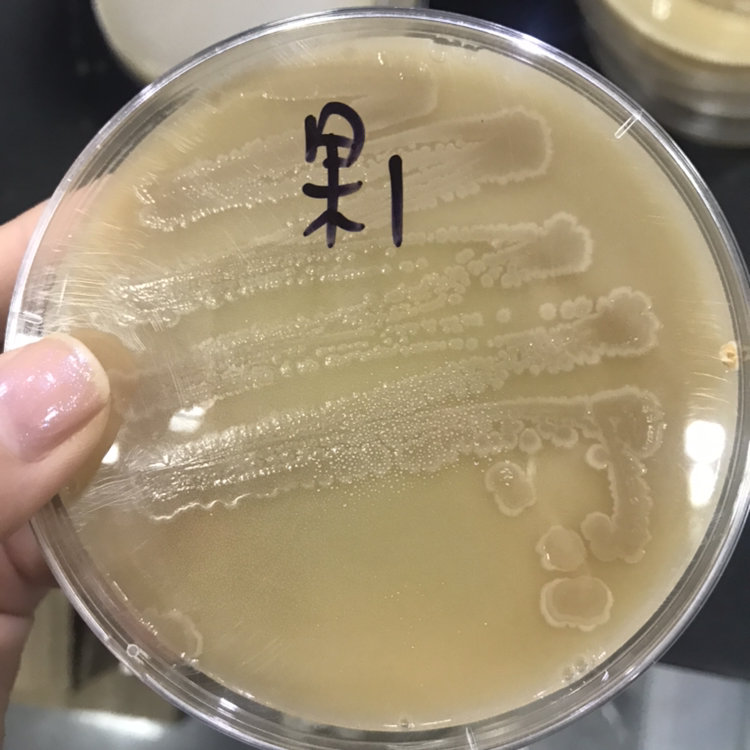
醋酸菌醋酸菌鉴定拜托大家了

醋酸菌菌落

菌落
图片尺寸3024x4032
醋酸菌醋酸菌鉴定拜托大家了
图片尺寸750x750
醋酸菌.jpg
图片尺寸450x295
a.酵母菌,乳酸
图片尺寸302x431
醋酸菌图册_百度百科
图片尺寸500x392
菌落形态确认
图片尺寸3120x4160
黄曲霉 黄曲霉菌菌落 黄曲霉菌分生孢子
图片尺寸1080x810
醋酸菌醋酸菌鉴定拜托大家了
图片尺寸750x750
菌落
图片尺寸375x500
一种耐热醋酸菌及其应用的制作方法
图片尺寸1000x911
醋酸菌醋酸菌鉴定拜托大家了
图片尺寸750x750
常见菌落-苏州长留净化科技有限公司
图片尺寸1280x960
醋酸菌
图片尺寸1200x857
醋酸菌
图片尺寸1200x857
一种改性聚丙烯腈正渗透膜的制备方法与流程
图片尺寸946x1000
资料常见微生物菌落形态
图片尺寸425x395
营养琼脂试了试化验室的菌落总数.平板上面长出来了像树枝的菌落.
图片尺寸1444x1221
这些细菌可不是有害的杂菌,它们叫做"醋酸菌",是对人类很有用的"工具
图片尺寸1019x524
醋酸菌
图片尺寸900x603
1 醋酸菌的定性试验根据碳酸钙透明圈的大小及菌落形态差异,从分离
图片尺寸630x264